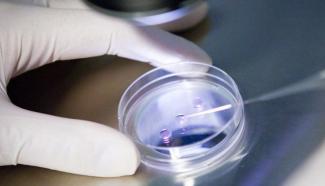

Του Χατζησυμεωνίδη Σταύρου
Μέλους Ε.ΑΣ.Υ.Α.
Φοιτητή Παντείου Πανεπιστημίου- Τμήμα Ψυχολογίας
Ένα βιοηθικό ζήτημα που αυξάνεται σταδιακά τα τελευταία χρόνια, εν αγνοία του πλήθους της κοινωνίας μας, είναι το δικαίωμα που κατέχει η γυναίκα στη σύγχρονη εποχή, να προβεί σε τεχνητή γονιμοποίηση μέσω ιατρικώς υποβοηθούμενης αναπαραγωγής, μετά τον θάνατο του συζύγου ή του άνδρα της με τον οποίο ήταν σε ελεύθερη ένωση, σύμφωνα με το άρθρο 1457 του ΑΚ.
Οι προϋποθέσεις, που πρέπει να πληρούνται σε αυτή την περίπτωση είναι οι εξής: α.) Να υπάρχει δικαστική απόφαση, που να ορίζει ότι δίνεται άδεια στη γυναίκα για να προχωρήσει σε τεχνητή γονιμοποίηση, χρησιμοποιώντας το γενετικό υλικό του αποθανόντα, εντός της οποίας να αναγράφεται συμβολαιογραφική πράξη που να ορίζει ότι ο άνδρας είχε δώσει εν ζωή την ρητή συγκατάθεση του στη μεταθανάτια γονιμοποίηση και επίσης να αναγράφονται ιατρικοί λόγοι, και συγκεκριμένα ότι ο άνδρας συνδέονταν με πιθανό κίνδυνο θανάτου ή με πιθανό κίνδυνο στειρότητας. Τέλος, η τεχνητή γονιμοποίηση θα πρέπει να διεξάγεται 6 μήνες μετά τον θάνατο του άνδρα, προφανώς διότι ο νομοθέτης θέλει να κατοχυρώσει πως μία τέτοια απόφαση δεν είναι βιαστική και επίσης εντός 2 ετών, εντός του οποίου περιθωρίου θα πρέπει να ολοκληρώνονται τα κληρονομικά ζητήματα του άνδρα προς τους κληρονόμους. β.) Η γυναίκα θα πρέπει να είναι επίσης κάτω των 50 ετών, για εύλογους υγειονομικούς λόγους.
Ερώτημα λοιπόν ανακύπτει, για το εάν το παιδί που θα γεννηθεί σε μία τέτοια περίπτωση, αδικείται προκαταβολικά, καθώς προγραμματίζεται η ανάπτυξη του χωρίς πατέρα. Επίσης, η κοινωνία μας είναι έτοιμη να δεχθεί ένα τέτοιο παιδί χωρίς να στιγματιστεί; Είναι προς το συμφέρον του;
Η θέση του νόμου, είναι ότι εφόσον επιτρέπονται οι μονογονεικές οικογένειες βάσει του άρθρου 1456 παρ.1 εδ. Β του ΑΚ, είναι προτιμότερο για το παιδί, να ρυθμιστεί νομικά αντί να αγνοηθεί αυτή η περίπτωση. Δυστυχώς όμως ο νόμος εστιάζει στην δημιουργία της μονογονεικής οικογένειας μέσω ιατρικώς υποβοηθούμενης αναπαραγωγής και όχι κατά κύριο λόγο στο επιτρεπτό της μεταθανάτιας γονιμοποίησης.
Συνεπώς αν αναλογιστεί κανείς πως η επικρατούσα κοινωνική αναπαράσταση στη χώρα μας, και μάλλον ορθά, ως προς το συμφέρον του παιδιού είναι να μεγαλώνει το παιδί και με τους δύο γονείς, κάτι τέτοιο άλλωστε ενισχύεται και από τον κλάδο της Αναπτυξιακής Ψυχολογίας αλλά και της Παιδιατρικής, ένα τέτοιο παιδί θα δυσκολευτεί να προσαρμοστεί στις επιταγές της καθημερινότητας. Αξίζει λοιπόν να αναλογιστούμε πέρα από κάθε προσωπική πεποίθηση και με αποκλειστικό κριτήριο το συμφέρον του παιδιού, την στάση μας & την συμπεριφορά μας απέναντι σε τέτοιους απογόνους, με μία λεπτή ανθρωπιστική προσέγγιση. Άλλωστε ο Θεσμός - ΕΛ. ΑΣ., είναι αυτός που προασπίζεται τα δικαιώματα των πολιτών, των φιλήσυχων ανθρώπων, πόσο μάλλον των παιδιών που θεωρούνται από τον νομοθέτη αδύναμα να υπερασπισθούν τα δικαιώματα τους. Είναι βιοηθική η υποχρέωση μας πρωτίστως ως κοινωνία να δεχτούμε σταδιακά και να μην στιγματίσουμε την ταυτότητα αυτών των απογόνων, κάτι που θα έχει καταστροφικές συνέπειες στην ψυχική τους υγεία και ως προέκταση ενδεχομένως και στην κοινωνία μας, αφού πρόκειται για εν δυνάμει πολίτες.
Απόσπασμα από την εφημερίδα της Ένωσης Αθηνών "Σύγχρονη Αστυνομία" που μόλις κυκλοφόρησε